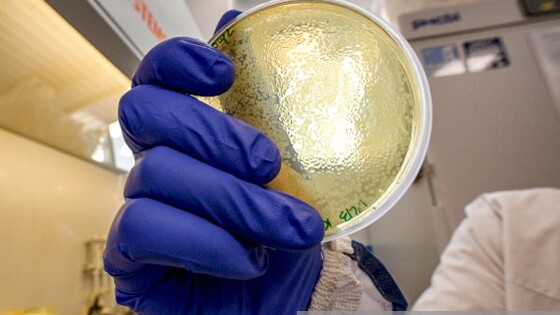

Биотехнолог Духовлинов: Искусственный интеллект можно научить делать вакцины
За годы конструирования работающих вакцин ученые выявили алгоритм, который намерены заложить в нейросеть для полной автоматизации процесса и совершенствования, заявил газете ВЗГЛЯД кандидат наук по специальности биохимия, биотехнолог Илья Духовлинов.
«Частная научная лаборатория под моим руководством занимается разработкой фармацевтических препаратов в течение последних 20 лет. За это время нами накоплен большой опыт создания успешных и неуспешных фармацевтических продуктов, в частности, в области создания генно-инженерных вакцин. Нами получены полностью доказавшие эффективность на соответствующих моделях рекомбинантные вакцины против пневмонии, папилломавирусов, туберкулеза, гриппа. Эти вакцины были протестированы независимыми организациями и получены положительные заключения о протективности», – говорит Духовлинов.
Годы такой работы позволили ученым выявить оптимальный «алгоритм» создания «работающей» вакцины. Раньше, во времена жизни двух величайших фигур в микробиологии француза Луи Пастера и немца Роберта Коха, считалось, что оптимальным будет использование живого, убитого или частично убитого (ослабленного) патогена. Современный шаг вперед, сделанный в научном коллективе собеседника, – это выбор необходимых участков патогена, которые создают протективный иммунный ответ.
«Результат – после живых вакцин мы можем иметь иммунный ответ на хрящевую ткань, белки мозга, рецептор инсулина и так далее. Современная генная инженерия позволяет удалить эти участки при конструировании рекомбинантных вакцин и сделать их полностью безопасными. Эти подходы являются уникальными и реализованы в разработках. Понимание этой технологии – очень непростая вещь. Здесь существует не только алгоритм, но и работы с разными базами данных, анализ третичных структур», – делится биотехнолог.
Он подчеркивает, что немаловажен опыт химика-дизайнера такой вакцины. Понимание опыта других научных групп и анализ массива данных литературы. Для того чтобы унифицировать этот подход, сделать его доступным для современной цивилизации, ученые решили обучить искусственный интеллект работать в области конструирования вакцин от любых патогенов, в том числе вновь возникших.
«Это очень непростая и интереснейшая задача. Наша научная группа расширилась, включив в себя IT-специалистов самого высокого класса. Начальный этап работы – это создание методик обучения искусственного интеллекта на основе данных, получаемых в биотехнологии. Это и научные статьи, и моделирование пространственных взаимодействий молекул, и обращение к базам данных, где хранятся геномы патогенов. Подробный проект реализуется впервые в мире, аналогов ему нет», – рассказывает Духовлинов.
На сегодня есть алгоритмы поиска Т- и В-клеточных эпитопов (участки белков патогена, которые узнаются разными клетками иммунитета) на основе нейронных сетей, продолжает специалист. Однако это не создание вакцин как таковое, но один из важных этапов конструирования вакцины, которое исполняется с помощью ИИ. Также существует нейронная сеть, которую учили делать вакцину от COVID-19, судьба которой пока неизвестна.
«Мы ожидаем, что получим IT-продукт, который будет способен решать проблемы создания новейших, безопасных, эффективных вакцин от инфекционных угроз, перед которыми может столкнуться человечество. Весь наш накопленный богатый опыт конструирования работающих вакцин, а также опыт других научных групп, будет аккумулирован в виде нейросети, которая будет самообучаться, совершенствоваться и служить человеку для защиты его здоровья. В последующих этапах мы планируем разработку подобных систем не только в области вакцинологии, но и других сферах фармакологии и медицины», – заключил собеседник.